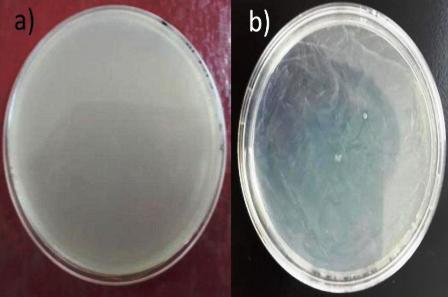
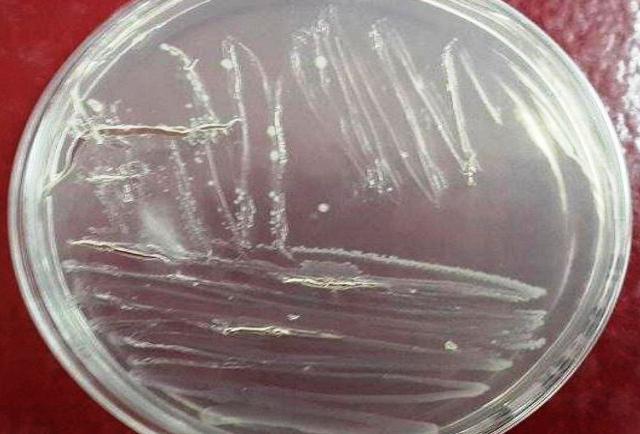

Técnicas básicas de siembra y observación de microorganismos
Se prepararon medios líquidos y sólidos para la siembra de microorganismos provenientes de un caldo con crecimiento. Durante la siembra en el medio sólido se emplearon técnicas como, la de incorporación de medio, la extensión en placas, y el aislamiento por estriado, observándose crecimiento en todos los casos. Sin embargo, solo se logró aislar el microorganismo en la siembra por estriado, señalando dicha técnica como la más efectiva para este fin. Por otra parte, para estudiar la morfología de las bacterias se prepararon distintas muestras, una húmeda en la cual solo se pudo apreciar la movilidad del microorganismo sin gran calidad ni contraste, y otras en seco preparando un frotis en el cual se fijaba la muestra al portaobjetos aplicando calor. En las preparaciones fijadas se usaron las tinciones de Gram, permitiendo distinguir entre bacterias gram positivas y gram negativas, la tinción simple y las tinciones de cápsula y esporas.
1. INTRODUCCIÓN
La microbiología es el estudio de los microorganismos, un grupo amplio y diverso de organismos microscópicos que existen como células aisladas o asociadas [1]. Inventos como el microscopio, los medios de cultivo, tinciones, pruebas y recuentos han sido pilares del desarrollo de la microbiología como ciencia [2], razón por la cual es necesario que se adquieran destrezas y que se conozcan los métodos básicos para después entrar en el campo de la investigación experimental. En este sentido, lo principal a tomar en cuenta para empezar a estudiar microorganismos es el medio en el que estos viven, crecen, o se piensa sembrar, llamado medio de cultivo, el cual es un conjunto de nutrientes, factores de crecimiento y otros componentes que crean las condiciones necesarias para el desarrollo de microorganismos [3]. Estos medios pueden ser de diferente composición, según las necesidades nutricionales del organismo que se busca crecer o aislar. En todo caso, se pueden clasificar por su estado como medios sólidos, y medios líquidos, según contengan o no agar respectivamente. Dado que los microorganismos son ubicuos (se pueden detectar casi en cualquier hábitat), los medios de cultivo y los instrumentos deben ser esterilizados antes de su empleo [3]. Esto con la finalidad de evitar contaminaciones al trabajar con un cultivo de microorganismos puro. En función de esto existen distintos métodos para llevar a cabo la esterilización, entendiéndose esta como la destrucción completa de todos los microorganismos, incluidas formas resistentes como esporas bacterianas, virus sin envoltura y hongos [4].
Otro aspecto clave para entender estos organismos es su caracterización en base a su morfología o fisiología, para lo cual es necesaria su observación. Es por ello que el microscopio se utiliza de forma rutinaria, ya que proporciona importante información para la identificación temprana y definitiva de los microorganismos [5]. Si bien durante la observación microscópica de muestras vivas o húmedas no es necesario tratamiento previo, en la mayoría de los casos se requiere usar tinciones. La tinción es un método sencillo para incrementar el contraste entre la célula y su entorno empleando colorantes, y por lo tanto mejorando la imagen observada [6].
En el presente estudio, se describe la preparación de algunos tipos de medios de cultivo, así como la comparación entre los métodos usados para su esterilización y las distintas técnicas empleadas para sembrar. Son también descritos algunos procedimientos para teñir preparaciones e identificar algunas muestras mediante la observación microscópica.
2. MATERIALES Y MÉTODOS
2.1. Preparación de un medio líquido
Se pesaron 0,31 g de caldo nutritivo (se requieren 0,8 g de este para preparar 100 ml de medio) en una balanza de precisión (Ohaus Adventurer Pro) y se traspasaron a una fiola agregándole 40 ml de agua destilada, agitando la mezcla hasta su homogenización. Luego se colocaron 10 ml de la mezcla (medio líquido) en tres tubos de ensayo distintos A, B y C respectivamente. Los 10 ml restantes se guardaron para su posterior utilización.
2.2. Preparación de un medio sólido
Un total de 0,6 de agar cuenta estándar (se requieren 2,35 g de agar cuenta estándar por cada 100 ml de agua destilada) fueron pesados en una balanza de precisión, los cuales se traspasaron a una fiola a la que se le agrego 25 ml de agua destilada.
2.3. Esterilización de medios de cultivo
El tubo A se colocó en un autoclave a 121 ºC por 15 min; el B se dejó en baño María a aproximadamente 100 ºC por 15 min; y el C se dejó a temperatura ambiente (tubo control). Los 10 ml restantes de la mezcla se traspasaron por filtrado a un tubo D ya esterilizado, mediante el uso de un filtro de membrana. El medio sólido fue también colocado en el autoclave a 121 ºC por 15 min.
2.4. Siembra
2.4.1. En un caldo nutritivo
Con una pipeta estéril se tomaron 200 μl de muestra de un caldo nutritivo con crecimiento de organismos agregándolo a 20 ml de otro caldo nutritivo previamente esterilizado.
2.4.2. En agar inclinado
Con un asa de platino esterilizada (calentada con el mechero) se tomó una porción de muestra de un caldo con crecimiento bacteriano, y se introdujo en un medio de agar inclinado haciendo en primera instancia una pequeña incisión en la superficie inferior del agar y después con un movimiento en zigzag se procedió a pasar el asa desde la parte inferior hasta la punta de la superficie del agar.
2.4.3. Por incorporación
Se tomó con una pipeta estéril 1ml de caldo con crecimiento y se colocó en el centro de una placa estéril agregándole posteriormente 25 ml de agar cuenta estándar esterilizado (aun liquido con una temperatura aproximada a los 37-40 ºC), agitando luego la placa de la siguiente forma:
• 4 veces en sentido horario
• 4 veces en sentidos anti-horario
• 1 vez hacia arriba y hacia abajo
• 1 vez hacia los costados
• 1 vez en sentido anti-horario
2.4.4. Por extensión
Con una pipeta estéril se tomaron 0,1 ml de la muestra de caldo con crecimiento, agregándolos en el centro de una placa con agar. Luego con un rastrillo previamente esterilizado con el mechero se procedió a distribuir uniformemente la muestra por toda la superficie del agar.
2.4.5. Por estriado
Con un asa de platino esterilizada, se tomó una muestra de un caldo con crecimiento, pasándolo por una placa sobre la superficie del agar sub-dividido en 3 o 4 cuadrantes, siguiendo este proceso:
1- se realizó movimientos de zigzag (o cualquier otro) sembrando todo lo posible la muestra por el primer cuadrante;
2- 2-se quemó el asa;
3- 3-se continuó desde donde terminó la siembra del primer cuadrante y se prosiguió a pasar el asa en todo lo posible por la superficie del segundo cuadrante;
4- Se volvió a quemar el asa y se continuó pasando el asa por la superficie del agar desde donde se terminó la siembra;
5- Así sucesivamente hasta que se acaben los cuadrantes.
2.5. Preparación de frotis, tinciones y observación microscópica
Todas las preparaciones realizadas fueron observadas al microscopio empleando el objetivo de inmersión, con la excepción de la preparación húmeda que uso 4000x de aumento.
2.5.1. Preparación húmeda
Se agregó 1 gota de cultivo sobre un portaobjetos y se cubrió con el cubreobjetos.
2.5.2. Frotis a partir de medio líquido
Con un asa estéril se colocó 1 gota de la muestra sobre el portaobjetos extendiéndola por toda el área previamente marcada con ayuda de un marcador indeleble en la parte inferior de este. Dejándose secar; una vez seco se pasó 3 veces por la llama del mechero para fijar la muestra.
2.5.3. Tinción simple
Se cubrió un frotis con cristal violeta por 5 min, luego se lavó con agua y se dejó secar. Otro frotis fue cubierto con safranina y también se dejó actuar por 5 min.
2.5.4. Tinción de gram
1-Se cubrió la preparación con cristal violeta 5 min y se lavó con agua;
2- Se le agregó lugol por 5 min y se volvió a lavar con agua;





Se observaron microorganismos alargados amarillentos moviéndose en línea recta dando vueltas sobre un eje de rotación.






3- Se agregaron 3 o 2 gotas de alcohol-acetona e inmediatamente se lavó con agua;
4- se cubrió la preparación con safranina por 5 min, se lavó con agua y se dejó secar.
2.5.5. Tinción de cápsulas
Se cubrió el frotis con safranina por 5 min, se lavó con agua y se dejó secar; una vez seco, se le agrego 1 gota de nigrosina por uno de los extremos del portaobjetos, y con ayuda de un segundo portaobjetos se realizó una extensión de la nigrosina por toda la superficie del portaobjetos con la muestra, dejándolo secar.
2.5.6. Tinción de esporas
Se colocó un papel de filtro sobre el frotis y se impregnó con verde malaquita. Se hizo pasar por el mechero varias veces hasta observar la emisión de vapores, cuidando no quemar la muestra ni secarla por completo, razón por la cual se agregaba más colorante a medida que se calentaba, realizando esto durante 10 min. Después se retiró el papel de filtro y se lavó con agua, para luego colorear con safranina durante 5 min, lavar y dejar secar.
3. RESULTADOS
3.1. Medios líquidos
Después de 24 horas los tubos A y B no presentaron ningún cambio en su composición, por lo que no hubo ningún crecimiento microbiano. El tubo C se tornó muy turbio, señalando la presencia de microorganismos, al igual que el tubo D que cambio un poco su coloración translucida indicando posible contaminación (Fig. 1).

Figura 1: Crecimiento microbiano en medio líquidos con distintos métodos de esterilización.
3.2. Siembra en medios líquidos y sólidos
3.2.1. En caldo nutritivo
El caldo nutritivo inoculado se tornó turbio, indicando la presencia de microorganismo en el medio (Fig.2).

Figura 2: siembra en caldo nutritivo
3.2.2. En agar inclinado
Se presentó un crecimiento de la muestra sobre la superficie del agar, y un poco en el interior del agar donde se había hecho la perforación con el asa (Fig. 3).

Figura 3: Crecimiento bacteriano en agar inclinado
3.2.3. Por incorporación
Presento una elevada concentración de la muestra y no se pudo distinguir ningún microorganismos (Fig. 4a).
3.2.4. Por extensión
No hubo presencia de microorganismos aislados de la muestra en la placa (Fig. 4b).
Figura 4: a) siembra por incorporación en placa; b) siembra por extensión de superficie
3.2.5. Por estriado
Se obtuvieron colonias aisladas de color blanco, del microorganismo presente en la muestra (Fig. 5).
Figura 5: Siembra de aislamiento por estría.
3.3. Observación de microorganismos en el microscopio
3.3.1. Preparación húmeda
Se observaron microorganismos alargados amarillentos moviéndose en línea recta dando vueltas sobre un eje de rotación.
3.3.2. Tinciones simples
En la preparación teñida con safranina se observaron bacilos coloreados de rojo (Fig. 6), y en la preparación con cristal violeta se detallaron cocos coloreados de azul-morado (Fig. 7)

Figura 6: Colonia de cocos teñidos con cristal violeta.

Figura 7: Colonia de bacilos teñidos con safranina.
3.3.3. Tinción de Gram
Se detallaron cocos coloreados de azulmorado, los gram positivos (Fig. 8) y bacilos coloreados de rojo, gram negativos (Fig. 9 ).

Figura 8: Cocos gram positivos.

Figura 9: Bacilos gram negativos.
3.3.4. Tinción de cápsulas
Se pudo observar un halo blanco alrededor de algunas bacterias (Fig. 10).

Figura 10: Cápsulas.
3.3.5. Tinción de esporas
Aparecieron manchas verdes correspondientes a las esporas (Fig. 11).

Figura 11: Endoesporas bacterianas.
4. DISCUSIÓN
4.1. Esterilización en de medios líquidos
El tubo A se esterilizo por calor húmedo, siendo el autoclave un mecanismo de esterilización muy eficaz debido a que puede alcanzar temperatura y presiones que desnaturalizan y destruyen todos los microorganismos incluidos las esporas [7], el tubo B tampoco presento crecimiento de bacterias, pero esto no quiere decir que el baño María funcione para esterilizar cultivos, ya que no puede destruir a las esporas, quizás en ese medio no se encontraban bacterias con esporas. El tubo C evidentemente presento crecimiento bacteriano ya que no se le aplico ningún mecanismo de esterilización o de desinfección que impidiera el desarrollo de esos microorganismos. Y el tubo D aunque se le realizo un filtrado con membrana el cual es muy eficiente para conseguir medios estériles ya que la mayoría de los microorganismos (excepto virus o micoplasmas) no pueden pasar por los poros del filtro [7], fue mucha la cantidad de medio líquido que se filtró (50 ml) por lo que es posible que los poros del filtro de membrana se taparan, causando un aparente crecimiento bacteriano, ya que se tornó un poco turbio, pero no tanto como el C.
4.2. Crecimiento microbiano por siembras
En la siembra en medio liquido (caldo nutritivo) la bacteria creció por todo el medio (cerca de la superficie del caldo, y alrededor de este, lo cual representa la turbidez del medio) lo que es indicativo de bacterias facultativas. Al igual que se vio con el crecimiento en agar inclinado, donde, además de crecer sobre la superficie del agar también hubo desarrollo bacteriano en el interior del agar, lo que quiere decir que puede resistir tanto a condiciones aeróbicas como anaeróbicas [8].
La siembras en placas, por incorporado y extensión, no se les logró aislar el microorganismos, debido probablemente al uso de una alta concentración de la muestra al momento de realizar la siembra. En cambio con el aislamiento por estrías si se logró aislar colonia, y eso se debe también a que esta técnica posee un grado de eficiencia mayor a las otras dos, por el hecho de que a medida de que se va agotando la muestra, se va quemando el asa con la que se siembra, reduciendo así la concentración de la muestra principal.
4.3. Preparaciones para el microscopio
4.3.1. Preparación húmeda
Las preparaciones húmedas en contraste con las preparaciones secas, permitieron la observación de los microorganismos estando vivos, u observación “in vivo” [6]. Al no usar ningún tipo de colorante, si aplicar calor, las bacterias no se ven afectadas y pueden estar vivas y moviéndose libremente en la preparación. La desventaja de este método es que cuesta enfocar una sola bacteria porque esta seguramente se mueve hasta otro sitio, además el bajo contraste en el microscopio de campo claro hace difícil la observación.
4.3.2. Tinción simple
Las tinciones se clasifican como simples cuando toda la muestra se tiñe del mismo color y se utiliza un sólo colorante [5]. Esto solo permite diferenciar la forma o morfología externa de la bacteria, y quizás su morfología colonial. La muestra teñida con safranina se asemejó morfológicamente a E.coli, por tener forma de bacilo y crecer en colonia. Por otra parte, la preparación teñida con cristal violeta, se asimilaba a Staphylococcus aureus, cocos gram negativos aglomerados [9].
4.3.3. Tinción de Gram
Es definida como una tinción diferencial, ya que utiliza dos colorantes y clasifica a las bacterias en dos grandes grupos: bacterias Gram negativas y bacterias Gram positivas [10]. Los bacilos de la muestra se tiñeron de rojo siendo estas las Gram negativas y los cocos de azul-morado las Gram positivas. La pared celular de las bacterias Gram negativas está constituida por una capa fina de peptidoglicano y una membrana celular externa, mientras que las bacterias Gram positivas poseen una pared celular gruesa constituida por peptidoglicano, pero no cuentan con membrana celular externa; así pues, la composición química y el contenido de peptidoglicano en la pared celular de las bacterias Gram negativas y Gram positivas explica y determina las características tintoriales [5]. Sucede que la pared celular de las bacterias Gram negativas no es lo suficientemente gruesa para impedir el paso del disolvente (alcohol-acetona) y el cristal violeta se lava, cosa que no pasa en las Gram positivas pues su membrana posee poros mucho más cerrados y es más gruesa. Después de que el cristal violeta es lavado en las Gram negativas, estas se tiñen con safranina, razón de coloración rojiza.
4.3.4. Tinción de cápsula
El principio es simple, la cápsula de las bacterias no se tiñe con la nigrosina, razón por la cual va a aparecer contrastada de color blanco sobre un fondo negro o morado como resultado del colorante anterior. En todo caso la principal dificultad con la tinción negativa es que los microorganismos tienden a contraerse durante el periodo de secado [5], razón por la cual resultó tan difícil su identificación.
4.3.5. Tinción de esporas
Las endosporas son estructuras de resistencia producidas por algunas bacterias gram positivas [1]. Y debido a la naturaleza de su envoltura, estas no son teñidas de manera convencional como otras estructuras de la bacteria. Es por esto que se calienta el colorante y se aplica por 10 min. Sucede que el calor modifica la permeabilidad de la endospora y permite la entrada del colorante a través de las capas externas [6], luego al lavar, se extrae el verde malaquita de todas las estructuras menos de las esporas y finalmente se tiñen el resto de las estructuras con algún colorante contraste, es por esto que las endosporas se ven verdes y el resto rojo o morado.
5. CONCLUSIONES
La técnica más eficaz para realizar una esterilización es el autoclavado, en comparación con la filtración, y el baño de María.
La técnica más eficiente para aislar cultivos puros de microorganismos es el sembrado en superficie por estrías o por agotamiento.
Las tinciones son herramientas clave para la caracterización y clasificación de un microorganismo. Las especies contenidas en las muestras de la tinción simple A y la tinción simple B eran probablemente S. aureus y E. coli respectivamente.
6. REFERENCIAS BIBLIOGRÁFICAS
[1] BROCK, Madigan M, Martinko J, Parker J. Biología de los microorganismos. Decima edición. Madrid: Pearson; 2003. p 1111.
[2] Toro D. Manual para la introducción al laboratorio de microbiología. Colombia: Editorial Universidad de Caldas; 2005. P 118.
[3] Gamazo C, López-Goñi I, Díaz R. Manual práctico de microbiología. Tercera edición. Barcelona: Editorial MASSON; 2005. p 235.
[4] Murray P, Rosenthal K, Pfaller M. Microbiología médica. Sexta edición. Barcelona: Editorial Elsevier; 2009. p 915.
[5] López-Jácome L, et al. Las tinciones básicas en el laboratorio de microbiología. Investigación en discapacidad. 2014: 3(1): 10-18.
[6] Vázquez A, Silóniz I, Serrano S. Técnicas básicas de microbiología: observación de bacterias. Reduca Serie Microbiología. 2010: 3(5): 15-38.
[7] Pérez-Uz B, et al. Metodologías de esterilización. Madrid: REDUCA; 2010. [8] Prats G. Microbiología Clínica. 5ta edición. Madrid: Editorial Médica Panamericana; 2006. p 489.
[9] Pahissa A. Infecciones producidas por Staphylococcus aureus. Barcelona: Editorial MARGE; 2009. p 198.
[10] Beveridge TJ. Use of the Gram stain in microbiology. Biotechnic & Histochemistry. 2001; 76: 111-118
This post has been voted on by the steemstem curation team and voting trail.
There is more to SteemSTEM than just writing posts, check here for some more tips on being a community member. You can also join our discord here to get to know the rest of the community!
Felicitaciones, un gusto no sólo leer el artículo, es del agrado observar la estructura y esquema que utilizaste, me gusto tu post sobre los aspectos de siembra y observación de microorganismos. Saludos
Muchas gracias por tu comentario, un abrazo.
¡Felicidades, #proconocimiento te valoró!
Has sido reconocido(a) por tu buen post por el Comité de Arbitraje y Valoración del Proyecto Conocimiento @proconocimiento.
Apoyamos y valoramos tu esfuerzo...
Proyecto Conocimiento es parte de la comunidad @provenezuela.
Pioneros en la plataforma #steemit en el reconocimiento y valoración a la Producción Intelectual en habla hispana.
muy interesante articulo.
Gracias, intentaré seguir haciendo lo que me gusta de la mejor forma que sé.